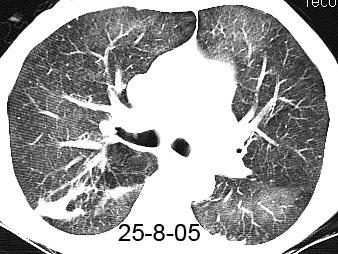
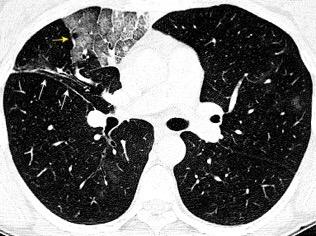
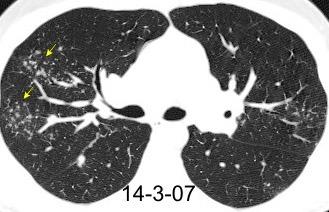

TÓRAX. SIGNOS Y PATRONES RADIOLÓGICOS.


PARTE I. PULMÓN.
*REVISADO Y
MODIFICADO 2-6-2024



SIGNOS Y PATRONES RADIOLÓGICOS. Parte 1. Pulmón*
3. ALAS DE MARIPOSA. SIGNO DE LAS
5. ALAS DE MARIPOSA. CORAZÓN NORMAL
6. ALAS DE MARPOSA. CRÓNICAS
7. ALAS DE MARIPOSA INVERTIDAS.
9. “AMETRALLADORA GATLING”. SIGNO DE LA
10. ANGIOGRAMA TC. SIGNO
11. ANILLO DE SELLO SIGNO DEL 12. ÁRBOL EN BROTES . PATRÓN
14. ARCADA, SIGNO DE LA
15. ARCO DE PUENTE, SIGNO DEL 16. “ARTERIA INTERLOBAR”. SIGNO
17. ASIMETRÍA PULMONAR, PATRÓN DE 18. ATELECTASIA. PRESENTACIÓN AGUDA
19. ATELECTASIA. SIGNOS DIRECTOS
20. ATELECTASIA. SIGNOS INDIRECTOS
21. ATELECTASIA. LÓB. INF. DCHO
54. CHERIOOS SIGNO DEL
55. CINTURA PLANA. SIGNO DE LA
56. CIMITARRA. SIGNO DE LA
57. COLA DE COMETA.SIGNO DE LA.
58. CONSOLIDACIÓN. PATRÓN DE
60. CUBITOS DE HIELO. SIGNO DE LOS
61. CÚMULO SARCOIDEO.SIGNO DEL
63. DEDOS DE GUANTE. SIGNO DE LOS
65. DEFICIENCIA EN �-1. ANTITRIPSINA
66. DENSIDAD DISMINUÍDA, LESIONES DE
68. DESPLAZAMIENTO BRONCOVASCULAR
69. DESPLAZAMIENTO CISURAL. SIGNO DEL
70. DESPLAZAMIENTO DE GRANULOMA, SIGNO DEL 71. EMPEDRADO, PATRÓN EN

107. MOSAICO, PATRÓNN
109. NEUMATOCELE. CAUSAS
110. NEUMONÍA POR COVID-19
111. NEUMONÍA LIPOIDEA
112. NEUMONÍA ORGANIZADA.
113. NEUMONITIS DE RADIACIÓN
114 . NIVEL HIDROAÉREO. SIGNO DEL

116. NÓDULOS CON CALCIO. METÁSTASIS
117. . NÓDULOS CON CALCIO. TUBERCULOMAS
118- NÓDULOS REUMATOIDEOS
119. “NUDILLO. SIGNO DEL 120. OPACIDADES MULTIFOCALES
122. PALOMITAS DE MAÍZ. SIGNO DE LAS

22. ATELECTASIA. LÓB. INF. IZQDO
23. VARIANTE LÍNGULA
24. ATELECTASIA LÓB. MEDIO
25. ATELECTASIA. LÓB. SUP. DCHO
26. ATELECTASIA. LÓB. SUP. IZDO
27. ATELECTASIA NO OBSTRUCTIVA. TIPOS
29. ATELECTASIA REDONDA
30. B6. SIGNO DEL 31. BORDE RECTO , SIGNO DEL
BRONCOGRAMA AÉREO.
35. BRONCOGRAMA MUCOSO. 38. BRONCOGRAMA “OSCURO. 39. BRONQUIO DE DRENAJE.
40. BRONQUIO “POSITIVO”. SIGNO DEL
42. CALCIFICACIÓN EN NÓDULO PULMONAR
43. CALCIFICACIONES PULMONARES. CAUSAS
CARCINOIDE. SÍNDROME 48. CAVITACIÓN. SIGNO DE LA
CAVIDAD CON MASA DENTRO
EN BROTES, PATRÓN
CISURAS, ANATOMÍA 53. CISURAS, GRASA EN

71. FLEISCHNER, SIGNO DE. (HILIO “GORDO”)
71. GALAXIA. SIGNO DE LA
73. GOLDEN. SIGNO DE
74. HALO. SIGNO DEL
77. HALO INVERTIDO SIGNO DEL
78. HAMARTOMA PULMONAR
79. HINCHAZÓN DEL LÓBULO. SIGNO DE LA 81. HINCHAZÓN DEL LÓBULO. INVASIÓN TUMORAL
82. HOLLEJOS DE UVA. SIGNO DE LOS 83. INFARTO PULMONAR. SEMIOLOGÍA
84. INFARTO PULMONAR. SIGNOS LOCALES
85. INTERFASE. SIGNO DE LA
86. JOROBA DE HAMPTON. SIGNO DE LA 90. KAPOSI. SARCOMA DE 91. LACERACIÓN PULMONAR. HALLAZGOS
93. LÍNEA BLANCA PLEURAL. SIGNO DE 94. LÍNEAS DE KERLEY. TIPOS
96 LIMPIADOR DE TUBERÍAS.SIGNO DEL 98. LÓBULO MEDIO. SÍNDROME DEL 99. LÖFGREN SÍNDROME DE
100. LUFTSICHEL SIGNO DEL
102. LUFTSICHEL DERECHO. SIGNO DEL 103. MASA PULMONAR. SEMIOLOGÍA
104. MENISCO. SIGNO DEL
105. MENTA POLO.SIGNO DEL. 106. MILIAR. PATRÓN
123. PANALIZACIÓN. PATRÓN EN 124. PANCOAST. SÍNDROME DE 125. PERLAS NEGRAS. AGRUPACIÓNES
126. PICO YUXTAFRÉNICO..SIGNO DEL 127. PULMÓN BLANCO UNILATERAL
129. QUISTE HIDATÍDICO. SIGNOS
130. QUÍSTICA LESIÓN. LINFANGIOLEIOMIOMATOSIS
131. LESIÓN QUÍSTICA. HISTIOCITOSIS
132. QUÍSTICA ÚNICA, LESIÓN
133. RAILES DEL TREN. SIGNO DE LOS
134. RAYOS DE SOL. SIGNO DEL
135. RENDU-OSLER SÍNDROME DE
136. SEPTAL (LINEAR). PATRÓN
137. SEPTAL BILATERAL. PATRÓN
138. SEPTAL UNILATERAL. PATRÓN
139. SEPTO ARROSARIADO. SIGNO DEL 140. SILUETA. SIGNO DE LA

143. SUELTA DE GLOBOS. SIGNO DE LA
144. SYER-JAMES-MCLEOD. SÍNDROME DE 145. TORMENTA DE NIEVE. SIGNO DE LA 146. TRAUMA. CONTUSIÓN PULMONAR
147. TRES (3) DENSIDADES . SIGNO DE LAS
148. TRIANGULO SUPERIOR. SIGNO DEL
149. VASO PROMINENTE. SIGNO DEL
150. VASO IRRIGANTE., SIGNO DEL
152. VÍAS DE TRANVÍA. SIGNO DE LAS
154. VIDRIO DESLUSTRADO, PATRÓN
156. WESTERMARK.SIGNO DE
157. WINDEMERE. SÍNDROME DE LADY

“ALAS DE MARIPOSA”. SIGNO DE
(Butterfly shadow sign).(También.
Bat´s
wing) Densidades perihiliares con preservación de las áreas periféricas

Matthay MA. Resolution of Pulmonary Edema. Thirty Years of Progress. Am J Respir Crit Care. 2014. Edema pulmonar
Cardinale L, et al. Revisiting signs, strengths and weaknesses of Standard Chest Radiography in patients of Acute Dyspnea in the Emergency Department. J Thorac Dis 2012

Dr. César Pedrosa
“ALAS
DE MARIPOSA”. SIGNO
DE (Butterfly shadow sign).(También. Bat´s wing) Densidades perihiliares con reservación de las áreas periféricas


Edema cardiogénico

10% de los pacientes con edema pulmonar

Presión vascular elevada en el pulmón.
“Hidrostático”
Ocurre con fallo rápido. Insuficiencia mitral aguda post IAM, Endocarditis séptica.

Edema no cardiogénico (SDRA)
Aumento de la permeabilidad vascular y epitelial



Matthay MA. Resolution of Pulmonary Edema. Thirty Years of Progress. Am J Respir Crit Care. 2014.

Cardinale L, et al. Revisiting signs, strengths and weaknesses of Standard Chest Radiography in patients of Acute Dyspnea in the Emergency Department. J Thorac Dis 2012
Dr. César Pedrosa
“ALAS DE MARIPOSA” . SIGNO DE . (butterfly shadow sign).(También. Bat´s wing)


Corazón normal

Edema no cardiogénico
Hemorragia/ IAM/CMV/ Drogas
Neumocistis
Electrolitos
Ahogamiento



Edema no cardiogénico. Ahogamiento. Se cayó borracho en una bañera de agua con lejía
Gregorakos L, et al. Near-drowning: clinical course of lung injury in adults. Lung. 2009.

Dr. César Pedrosa
Dr. César Pedrosa
“ALAS DE MARIPOSA” (También. Bat´s wing) SIGNO
DE
Crónicas
Proteinosis alveolar






Silicosis
Sarcoidosis
Radiación
Neumonía organizada Muller Nl. High-yield Imaging.2010/Stern. ddx. 2011
Proteinosis alveolar

Acumulación de material rico en proteínas y lípidos parecido al surfactante en el parénquima. Arquitectura conservada


Dr. César Pedrosa
“ALAS DE MARIPOSA INVERTIDAS”. SIGNO DE
Reverse bat-wing sign
Consolidaciones periféricas con exclusión de las áreas perihiliares.


Asma. Eosinofilia

Trauma (Contusión)
Enf. Eosinofílica
Neumonía organizada Infartos
Distrés respiratorio agudo
Neumonitis por radiación
Enf. vascular del colágeno
Embolismo graso
Carr RB. Peripheral distribution (Reverse “bat-wing” ) . en Stern-Gurney. Expert ddx. Chest 2011





Dr. César Pedrosa
“ALAS
DE MARIPOSA INVERTIDAS”

CONSOLIDACIÓN



Consolidaciones no segmentarias bilaterales Patrón “butterfly negativo”.



Neumonía eosinófila
RX..50%. TC. 90% Más frecuente en Lób. Sup.
A veces, Lób. Inf.
Souza CA et al. Drug-Induced Eosinophilic Pneumonia: High-Resolution
CT Findings in 14 Patients. AJR 2006


Dr. César Pedrosa
AMETRALLADORA. SIGNO DE LA (“Gatling
Proyección lateral:

En la atelectasia del lóbulo superior, los bronquios dilatados y recolocados tienden a colocarse en forma circular.

Fisher M. Hilar eyes or the Gatling gun revisited.



gun sign”).

Atelectasia
LSD por Tb







Gatling gun
ANGIOGRAMA TC
Visualización de los vasos pulmonares sobre un fondo de pulmón sin aire, en TC con contraste.
51 pacientes




Consolidación sin obstrucción……………………….20
Neumonía/Neumonitis con obstrucción central…19

Atelectasia pasiva……………………………………….7
Impacto mucoso, neumonía lipoidea, linfoma pulmonar, hemorragia, Ca “alveolar”………..1 cada

Ca “bronquioalveolar, descripción inicial +90%)

Murayama S, et al: CT angiogram sign in obstructive pneumonitis and pneumonia. J Comput Assist Tomogr.1993/ Shah RM et al. CT angiogram sign: incidence and significance in lobar consolidations evaluated by contrast-enhanced

ANILLO DE SELLO. SIGNO DEL



(Signet ring sign)







Fallo: Presencia de hipertensión pulmonar que aumenta el tamaño de las arterias pulmonares.
McGuinness G et al. CT of airways disease and bronchiectasis. Radiol Clin N Amer 2002. Indicativo de bronquiectasias. Un bronquio, a cualquier nivel, mayor que su arteria pulmonar acompañante.

Dr. César Pedrosa
PATRÓN DEL “ÁRBOL EN BROTES”
Bronquiolos terminales rellenos de pus, caseum, líquido o células




Walker CM et al. Imaging Pulmonary Infection: Classic Signs and Patterns. AJR. 2014

Agudas

Bronconeumonía

Bronquiolitis infecciosa
Crónicas
Tuberculosis
Bronquiolitis folicular y infecciosa
Aspiración Panbronquiolitis difusa
Adenocarcinoma.

“Embolismo tumoral”
TB. probada. Adenocarcinoma gástrico

Dr. César Pedrosa
PATRÓN DEL “ÁRBOL EN BROTES”
(Tree in bud)
Crónicas
Panbronquilitis difusa

Aspiración
Tb. Endobronquial Micobacteria atípica
Bronquiectasias
Fibrosis quística
Ca bronquioalveolar




Metástasis intravascular





Dr. César Pedrosa
ARCADA. (Arcade-like sign ) SIGNO DE LA


La fibrosis perilobular sería responsable de la existencia de densidades arciformes alrededor de los lobulillos secundarios y que pueden llegar a la superficie pleural








Colza. Densidades alveolo-intersticiales periféricas. Neumonía intersticial inespecífica
Chiarenza et al. Chest imaging using signs, symbols, and naturalistic images: a practical guide for radiologists and non-radiologists. Insights into Imaging. 2019.

Dr. César Pedrosa
ARCO DE PUENTE. SIGNO DEL
Tendencia de los infiltrados subpleurales en neumonía por COVId-19 a presentar arcos que miran hacia la pleura. Según los autores, el signo más fiable con infiltrados subpleurales y dilatación de los vasos)








Wu R et al.. The arch bridge sign: a newly described CT feature of the coronavirus disease -19 (COVID-19) pneumonia. Quant Imaging Med Surg 2020
Dr. César Pedrosa
ARTERIA .“INTERLOBAR”. SIGNO DE LA
Art. descendente derecha






Art. interlobar Normal TEP 18,5 mm Aumento en PA de la arteria interlobar. Signo poco frecuente de la existencia de TEP.





Palla A et al. Enlargement of the Right Descending Pulmonary Artery in Pulmonary Embolism. AJR. 1983/Piazza G et al. Acute pulmonary embolism. Part I. Epidemiology and Diagnosis. Circulation 2006
Dr. César Pedrosa
ASIMETRÍA PULMONAR
1. Cirugía previa
2. Atelectasia (a menudo ignorada)
3. Tapón mucoso (agudo)
4. Atresia bronquial 5. Hipoplasia pulmonar 6. < Vascularidad pulmonar
p. ej. Swyer-McLeod





Colapsos del segmento apical-superior y del medial del LID. Aneurisma del seno de Valsalva









Coágulo/Cuerpo extraño
Trauma. (rotura bronquial)
Edema (Neum. por Micoplasma) Miyashita N et al. Infect Chemother. 2013
Bronquitis “plástica”
Patil MH et al. Respir Med Case Rep. 2016










SIGNOS DIRECTOS


1. Desplazamiento cisural





2. Apelotonamiento de estructuras broncovasculares

Dr. César Pedrosa
ATELECTASIA. SIGNOS INDIRECTOS


Los signos “clásicos” de la atelectasia sólo son visibles en los grandes colapsos pulmonares












ATELECTASIA DEL LÓBULO INFERIOR DERECHO















C M Mazas
C M Mazas
Dr. César Pedrosa
ATELECTASIA DEL LÓBULO INFERIOR IZQUIERDO














C M
Mazas
C M Mazas
C M Mazas
Dr. César Pedrosa
VARIANTE: aislada de língula















Mazas
Mazas


ATELECTASIA DEL LÓBULO MEDIO DERECHO












Mazas
Mazas
Dr. César Pedrosa




LOBULO SUPERIOR DERECHO











Mazas
Mazas
Dr. César Pedrosa
ATELECTASIA




LOBULO SUPERIOR IZQUIERDO










6 Fumadora con masa parahiliar izquierda. Ca microcítico. Múltiples familiares con Ca. de pulmón.

Dr. César Pedrosa



Compresiva Masa, Derrame










“Redonda”

Dr. César Pedrosa
ATELECTASIA NO OBSTRUCTIVA.
Pasiva


< volumen pulmonar debido a la capacidad de retracción elástica (“recoil”),del pulmón en presenciade un neumotórax no tabicado. Müller NL.2001
Cicatricial



Adhesiva



Pérdida de volumen pulmonar debida a contracción del tejido intersticial.. Müller NL.2001


< volumen pulmonar debida a déficit de surfactante. Müller NL.2001

Dr. César Pedrosa
ATELECTASIA REDONDA
No rara. 85% hombres 65% exposición al asbesto


Asociada a Fallo cardiaco Infarto pulmonar Sínd. de Dressler
Derrame pleural paraneumónico, TB, etc.



Cho SR et al. Round (helical) atelectasis. Brit J Radiol.1981;54:643-650







“B6”, SIGNO DEL





Visualización del bronquio del segmento ápicosuperior del lóbulo inferior por consolidación alrededor de él.
Tuberculosis
Friedman PJ. Radiology of the superior segment of the lower lobe: a regional perspective introducing the B6 bronchus sign. Radiology 1981










BORDE RECTO. “SIGNO DEL
(Straight edge sign)



La ausencia uni o bilateral de un límite bien definido de la panalización en cortes coronales ha sido asociada a la neumonitis intersticial usual.(NIU)
Bilateral: (Valor predictivo positivo 96,7).



Fibrosis pulmonar NIU por biopsia. Signo del borde recto en el lado derecho.



Zhan X et al. Differentiating Usual Interstitial Pneumonia From Nonspecific Interstitial Pneumonia Using High-resolution
Computed TomographyThe “Straight-edge Sign”. Journal of Thoracic Imaging: 2018

Dr. César Pedrosa
BRONCOGRAMA AÉREO





Bronquios rellenos de aire sobre un fondo de pulmón sin aire debido a:
a) Reabsorción en atelectasia
b) Reemplazamiento en neumonía, hemorragia, etc.
c) Combinación de ambas
d) Expansión intersticial exagerada



Fleischner FG. The visible bronchial tree; a roentgen sign in pneumonic and other pulmonary consolidations. Radiology 1948
Hansell DM et al. Fleischner Society: Glossary of Terms for Thoracic Imaging. Radiology 2008

Dr. César Pedrosa
BRONCOGRAMA AÉREO
Neumonía por Neumococo. (Broncograma visible a través de derrame pleural)


Neumonía
Edema pulmonar
Atelectasia no obstructiva

Hemorragia
Infarto
Ca.
”broncoalveolar”
Linfoma
“Normal” (espiración)



Walker CM et al. Imaging Pulmonary Infection: Classic Signs and Patterns. AJR. 2014 Collins J. CT signs and patterns of lung disease. Radiol Clin N Am 2001




Dr. C Pedrosa
BRONCOGRAMA
“Forma” del broncograma
“Normal” “Rígido”

Neumonía…....60,87%
Tuberculosis. 32,56%

Ca. de pulmón. 25,64%


Ca. de pulmón. 64,10%%
Neumonía…....41,86%
Tuberculosis. 39,13%


“Tortuoso”

“Normal”

Neumonía…....60,8%
Tuberculosis. 25,5%
Ca. de pulmón. 7,69%
“Lumen” del broncograma
“Estenosis”

Ca. de pulmón. 82,05%%
Neumonía…....21,74%
Tuberculosis. 25,58%
Ca. de pulmón. 10,26%
Neumonía….....0%

“Expansión”

Tuberculosis. 20,93% Tuberculosis. 44,19%
Neumonía….....13,04%
Ca. de pulmón. 7,69%%

Qu H et al. The value of the air bronchogram sign on CT image in the identification of different solitary pulmonary consolidation lesions. Medicine 2017
Dr. César Pedrosa
BRONCOGRAMA “MUCOSO”. SIGNO DEL (DROWNED LUNG SIGN)

Obstrucción bronquial con remplazamiento del aire de los bronquios afectados por líquido.(moco)








Dr. César Pedrosa
BRONCOGRAMA “MUCOSO”. SIGNO DEL (DROWNED LUNG SIGN)

Obstrucción aguda bronquial con remplazamiento del aire de los bronquios afectados por líquido.(moco). Metástasis adrenal derecha










Dr. César Pedrosa
“MUCOSO”. SIGNO DEL (DROWNED LUNG SIGN)
Obstrucción aguda bronquial con remplazamiento del aire bronquial por líquido. Cuando es crónica, se puede acompañar de hinchazón del lóbulo.





Ca. epidermoide







Dr. César Pedrosa
BRONCOGRAMA “OSCURO”
SIGNO DEL (dark bronchus sign)

Visualización de un bronquio más oscuro que el parénquima que le rodea.




VIH+. Neumonía Neumocistis y Klebsiella
Se debe a la presencia de consolidación sutil en vidrio deslustrado.
(Signo de la silueta)
Se ha descrito en casos de neumonía por Pneumocystis jirovecii



Yadav P et al. The 'dark bronchus' sign: HRCT diagnosis of Pneumocystis carinii pneumonia. Ann Thorac Med. 2007
Gruden JF et al . High-resolution CT in the evaluation of clinically suspected Pneumocystis carinii pneumonia in AIDS patients w ith normal, equivocal or nonspecific radiographic findings. AJR 1997

MiniP
MiniP
Dr. César Pedrosa
BRONQUIO DE DRENAJE SIGNO DEL
Visualización de un bronquio en estudio convencional debido a el engrosamiento de sus paredes







Benigno Maligno Engrosamiento bronquial “Bronquio de drenaje”
Honda O et al. . Pulmonary cavitary nodules on computed tomography: differentiation of malignancy and benignancy.JCAT. 2007




Tb endobronquial
Dr. César Pedrosa
Dr. César Pedrosa
BRONQUIO POSITIVO SIGNO DEL Positive bronchus sign



Un bronquio con aire que termina abruptamente en una masa o nódulo periférico.
Frecuentemente visto en carcinoma con crecimiento lepídico y adenocarcinoma
Chiarenza et al. Chest imaging using signs, symbols, and naturalistic images: a practical guide for radiologists and non-radiologists. Insights into Imaging. 2019.
Anantham EA. Bronchus sign on CT scan rediscovered. Chest 2010






LM : Adenoca. predominantemente acinar. Tiene un 2º en LSD.
Adenocarcinoma de crecimiento lepídico



BRONQUIO POSITIVO. SIGNO DEL
Positive bronchus sign
Un bronquio con aire que termina abruptamente en una densidad periférica.


Las lesiones inflamatorias crónicas como Tb pueden presentar engrosamiento de las paredes de un bronquio que remeda este signo. (“bronquio de drenaje”).
El broncograma puede prolongarse dentro de la lesión






Anantham EA. Bronchus sign on CT scan rediscovered. Chest 2010
Absceso pulmonar por Rothia mucilaginosa.(saprofito habitual). Gram+,



CALCIFICACIÓN. NÓDULO.

Nódulo < de 3cms y con estos tipos: Probabilidad de ser benigna:+/-100%. Winer-Muram





Difusa Granuloma
Amiloidosis
Metástasis
Granuloma Hamartoma



“Palomitas de maíz” Hamartoma Laminar Granuloma Parásitos

Dr. César Pedrosa
Patogenia (Chan ED et al. Amer J Respir Crit Care Med. 2002)


CALCIFICACIONES/OSIFICACIONES PULMONARES
*Índice

1. Distrófica. Deposición de sales de calcio en tejido pulmonar anormal. (necrótico/fibrótico)
Tuberculosis

Granulomatosas (Tb, Sarcoidosis) Infec. Viral (Post-varicela, Viruela)
Parasitarias (Neumocistis, Paragonomiasis, QH)
Amiloidosis







CALCIFICACIONES/OSIFICACIONES PULMONARES
Patogenia (Chan ED et al. Amer J Respir Crit Care Med. 2002)
2. Metastática. Deposición de sales de calcio en tejido normal debido a balance anormal iónico mineral.

Causas malignas
Ca. paratiroideo
Mieloma múltiple
Linfoma/leucemia
Ca. Epidermoide hipofaríngeo
Sarcoma sinovial
Ca. de mama
Coriocarcinoma

Ca. de mama









Patogenia (Chan ED et al. Amer J Respir Crit Care Med. 2002)
3. Osteogénica (Formación ósea).
A. Idiopática
B. Patología pulmonar pre-existente
Fibrosis idiopática

Amiloidosis


CALCIFICACIONES/OSIFICACIONES PULMONARES
*Índice

Busulfán. (Administración crónica)
Distres respiratorio agudo
Hamman-Rich
Sarcoidosis/Tuberculosis
Metástasis de Ca. de mama
Melanoma
Sarcoma osteogénico.






Sarcoma
sinovial de pelvis
CALCIFICACIONES/OSIFICACIONES PULMONARES
Patogenia Chan ED et al. Amer J Respir Crit Care Med. 2002) Insuficiencia renal con hiperparatiroidismo 1º. Lesión mitral.
2. Metastática. Deposición de sales de calcio en tejido normal debido a balance anormal iónico mineral.

Causas benignas
Insuf. Renal crónica (hemodiálisis)

Trasplante hepático ortotópico
Hiperparatiroidismo primario
Administración exógena excesiva de Ca++ y Vit. D
Osteopetrosis/ Enfermedad de Paget









CARCINOIDE. SÍNDROME
Síndrome paraneoplásico por serotonina y otras hormonas.
Diarrea (70%), rubefacción de cara (90%) y tronco.
(Comienzo súbito. Puede ocurrir varias veces al día.





Disnea (15%) y broncoespasmo.
Suele ser necesaria la presencia de metástasis hepáticas para que ocurra el síndrome.

La serotonina puede estimular crecimiento de fibroblastos y producir fibrosis cardiaca con afectación de válvulas.
(Regurgitación tricuspídea o pulmónica)

Gade et al. Carcinoid Syndrome: A Review. Cureus 2020/Jin C et al. Carcinoid Heart Disease: Pathophysiology, Pathology, Clinical Manifestations, and Management .Cardiology 2021

T. Carcinoide de pirámide basal izda. Metástasis hepáticas








CAVITACIÓN. SIGNO DE LA (Necrosis)

Criptococo
Penicil. marffenei
Pneumoc. jiroveci

Neumonía necrotizante
Estafilococo, Klebsiella, Enterobacter, Neumococo, Nocardia Pseudomonas, Tb. (Típica y atípica)
Hemophilus influenza Actinomices.
Rodococo equis
M. complex
Micobacteria TB Neumococo.



Sarcoma Kaposi
Linfoma primario
Zhi-jian Yu et al. International Journal of Infectious Diseases. 2015
Gadkowski LB .CLINICAL
MICROBIOLOGY REVIEWS. 2008



VIH+. Neumonía neumocócica cavitada del LSD y LM.

Dr. César Pedrosa
CAVIDAD CON MASA DENTRO. SIGNO DE Crónica

Aire alrededor de una masa dentro de una cavidad.
Habitualmente cavidad antigua tuberculosa en paciente inmunocompetente.

Micetoma
Aspergillus
Candida Coágulo
Pus espeso
Membranas QH.
Tej. Necrosis
Aspergilosis inv.








Decúbito supino
Dr. César Pedrosa
PATRÓN CENTRILOBULILLAR





En relación con estructuras centrolobulillares.(Vasos).
Pueden verse en enfermedad del espacio aéreo o intersticial.
Distribución:
Centro del lobulillo.
Tamaño: 1 ms. +/ - 1 cm
No contacto con pleura visceral. Mal o bien definidos
Paciente con “6 cotorras”


Causas agudas
Neumonitis de hipersensibilidad
Bronquiolitis respiratoria

Edema pulmonar
Vasculitis


PATRÓN CENTRILOBULILLAR
CON ÁRBOL EN BROTES
Neumonía bacteriana + bronquitis infecciosa

Micobacterias
Aspiración
Aspergilosis alérgica
Fibrosis quística
Panbronquiolitis difusa




Bronconeumonía por Pseudomonas
Neoplasia endobronquial (Especialmente. Ca BrA.)




Dr. César Pedrosa
Dr. César Pedrosa
CISURAS. ANATOMÍA



Cisuras: Frecuencia







Cisuras horizontales: derecha e izquierda
Dr. César Pedrosa
CISURAS. GRASA EN




Lipomatosis

Grasa simulando atelectasia del lóbulo medio



K et al. Radiographic and CT Appearances of th Major Fissures. Radiographics 2001

Hayashi
Dr. César Pedrosa
CHERIOOS. SIGNO DEL
Nódulo pulmonar que contiene una pequeña cavidad.


Descrita en adenocarcinoma de bajo grado, carcinoma invasivo con crecimiento lepídico.
Se ha visto también en histiocitosis de Langerhans




LLC: Nódulo que crece en LSI. Punción: Adenoca. poco diferenciado


Lee KS et al. (1997) Bronchiolalveolar carcinoma: clinical, histophatologic, and radiologic findings. Radiographics.1997/ 21. Reed SL. Cheerios in the chest. Chest 1993/Chiarenza A et al. Chest imaging using signs, symbols, and naturalistic images: a practical guide for radiologists and non-radiologists. Insights into Imaging. 2019 .
Dr. César Pedrosa


CINTURA PLANA. SIGNO
DE LA “Flat


waist sign”

Cintura vascular estrecha. Rotación cardiaca debido a atelectasia del lóbulo inferior izquierdo











Traqueobroncomegalia con neumonía de LII.
Kattan KR and Wiot J F. Cardiac rotation in left lower lobe collapse. "The flat waist sign“. Radiology. 1976


Dr. César Pedrosa
CIMITARRA. SIGNO DE LA
Scimitar sign






Anomalía congénita caracterizada por shunt izquierda-derecha debido a retorno venoso anómalo



Asociada frecuentemente a hipoplasia pulmonar. El vaso anómalo es visible paralelo al borde cardiaco derecho. Robicsek F,1962. citado por Chiarenza et al. Chest imaging using signs, symbols, and naturalistic images: a practical guide for radiologists and non-radiologists. Insights into Imaging. 2019.
HIpoplasia pulmonar derecha con cimitarra que drena en aurícula izquierda.
Secuestro parcial con irrigación sistémica

Dr. César Pedrosa
COLA DE COMETA SIGNO
DE LA
(Comet-tail sign)
Estructura curvilínea que se extiende a partir de una atelectasia redonda

Se debe a la distorsión de vasos y bronquios.


Atelectasia redonda: Relación con exposición asbestos.(70%)








Dr. César Pedrosa
CONSOLIDACIÓN PATRÓN DE
Opacidad pulmonar de bordes imprecisos.
Excepción: La consolidación llega hasta una cisura.

(A menudo con broncograma aéreo)






Válvula aórtica intervenida. Neumonía por Estreptococo pneumoniae





PATRÓN DE CONSOLIDACIÓN


Bronquios rellenos de aire sobre un fondo de pulmón sin aire debido a:


a) Reabsorción en atelectasia
b) Reemplazamiento en neumonía, hemorragia, etc.
c) Combinación de ambas
d) Expansión intersticial exagerada


CAUSAS
Neumonía
Edema pulmonar
Atelectasia no obstructiva
Hemorragia

Infarto Ca. ”broncoalveolar”
Linfoma
“Normal” (espiración)
Fleischner FG. The visible bronchial tree; a roentgen sign in pneumonic and other pulmonary consolidations. Radiology 1948
Hansell DM et al. Fleischner Society: Glossary of Terms for Thoracic Imaging. Radiology 2008

Dr. César Pedrosa
“CUBITOS
DE HIELO”. SIGNO DE LOS (Melting sign)


Desaparición “concéntrica de los infartos pulmonares.








Woesner MB et al.. THE MELTING SIGN IN RESOLVING TRANSIENT PULMONARY INFARCTION. AJR. 1971.
Dr. César Pedrosa
CÚMULO SARCOIDEO . SIGNO DEL
(“Cluster” sign)







Múltiples nodulillos puntiformes formando un grupo en el pulmón periférico en pacientes con sarcoidosis

Dr. César Pedrosa



sign)

CÚMULO SARCOIDEO . SIGNO DEL (“Cluster”


De 91 pacientes con sarcoidosis, 9 (6 varones y 3 mujeres, con edad media de 29 an os) presentaban el ‘‘signo del cúmulo sarcoideo’’
Sarcoidosis

Dr. César Pedrosa
DEDOS DE GUANTE. SIGNO DE LOS
(Finger in glove sign)







Densidades tubulares ramificadas que parecen emanar del hilio y que representan bronquios dilatados y rellenos de moco.

Walker CM et al. Imaging Pulmonary Infection: Classic Signs and Patterns. AJR 2014

Dr. César Pedrosa
DEDOS DE GUANTE. SIGNO DE LOS
(Finger in glove sign)

Aspergilosis broncopulmonar alérgica
Asma
Fibrosis quística



También en:
Tum. endobronquial
Atresia bronquial
Bronquiectasias post inflamación






10
más tarde
Aspergilosis broncopulmonar alérgica

Dr. César Pedrosa
Dr. César Pedrosa
DEFICIENCIA
�-1. ANTITRIPSINA.
Lesión hereditaria con afectación de hígado y enfisema pulmonar.
Asociación: Asma Bronquiectasias. Riesgo alto de EPOC.

> 40% tos con expectoración




Predominio basal del enfisema aunque puede ocurrir en todo el pulmón.






DENSIDAD DISMINUIDA


1.Cavidad

Espacio aéreo de pared irregular post consolidación. También en nódulo o masa
A. FOCAL. Definición

2.Quiste Área de atenuación disminuida con interfase definida con el pulmón normal



3.Bulla

Hansell DM et al. Fleischner Society: Glossary of Terms for Thoracic Imaging. Radiology. 2008/. Chan C et al. Imaging of Cystic Lung Disease. Radiol Clin N Am 2022 .
Un espacio aéreo mayor de 1 cm, muy bien definido, por una pared muy fina, no superior a 1 mm. A menudo, con otras.

Dr. César Pedrosa
DENSIDAD DISMINUIDA. LESIONES DE
A. FOCAL. Patrones









Enfisema. Espacios aéreos aumentados con destrucción de paredes alveolares Bronquiectasias. Dilatación sacular de bronquios irreversible Neumatocele. Espacio aéreo de pared fina, en general, 2º a neumonía o trauma Panal. Tejido fibrótico con espacios quísticos de pared gruesa, subpleurales Hansell DM et al. Fleischner Society: Glossary of Terms for Thoracic Imaging. Radiology. 2008/. Chan C et al. Imaging of Cystic Lung Disease. Radiol Clin N Am 2022 .

Dr. César Pedrosa
DESPLAZAMIENTO BRONCOVASCULAR.


SIGNO DEL + “Reorientación Las estructuras broncovasculares se reorientan en caso de pérdida de volumen, lo que hace que a veces sean visibles en los estudios convencionales.










Dr. César Pedrosa
Dr. César Pedrosa
Dr. César Pedrosa
DESPLAZAMIENTO CISURAL. SIGNO DEL
Displacement of the interlobar fissures

Visualización de las cisuras interlobares desplazadas por la pérdida de volumen en atelectasias



Woodring JH et al. Types and mechanisms of pulmonary atelectasis . J Thorac Imaging . 1996









Dr. César Pedrosa
DESPLAZAMIENTO DE GRANULOMA SIGNO DEL
The shifting granuloma

Desplazamiento progresivo de un granuloma al perder el volumen pulmonar por atelectasia

Rohlfing B. The Shifting Granuloma:An Internal Marker of Atelectasis. Radiology 1977

14-4-03




Atelectasia del LSI por Ca. de pulmón.





PATRÓN EN “EMPEDRADO”.
(“Crazy paving”)
Exudados alveolares + infiltración de paredes alveolares y septos interlobulillares
Agudas

Edema pulmonar
Neumocistis jiroveci
Micoplasma pneumoniae
Influenza
Hemorragia
Wegener, Churg-Strauss
Neumonía eosinófila
Neumonitis post-rádica




Pneumocistis jiroveci en SIDA
De Wever W et al .The crazy-paving pattern: a radiological-pathological correlation. Insights Imaging. 2011/ Ye Z et al. Chest CT manifestations of new coronavirus disease 2019 (COVID-19): a pictorial review. Eur Radiol 2020






Dr. César Pedrosa
PATRÓN EN “EMPEDRADO”.
(“Crazy paving”)
Crónicas
Adenoca. mucinoso
Proteinosis alveolar
Sarcoidosis

Neumonía organizada
Neumonía lipoidea
Distrés respiratorio
Síndromes
hemorrágicos
N. Intersticial.(NINE)



Idiopática 90%. Congénita 2%.







Proteinosis alveolar
Rossi SE
Asociada exposiciones a polvo, agentes químicos, linfoma, leucemia mieloide o neumonía por Neumocistis. ( 5-10%)

Dr. César Pedrosa
FLEISCHNER, SIGNO DE “PLUMP HILUS”
Infarto pulmonar en TEP
Gran trombo obliterando

las ramas derechas de la APD.

Sensibilidad…..20%
Especificidad..80%

Worsley DF. Radiology 1993







Worsley DF et al. Chest Radiographic Findings in Patients with Acute Pulmonary Embolism: Observations from the PIOPED Study. Radiology 1997/ Fleischner FG. Roentgen diagnosis of pulmonary embolism. Heart Bull . 1961.
Dr. César Pedrosa
“GALAXIA”. SIGNO DE LA



“Agrupación de granulomas” coalescentes formando un nódulo/masa rodeado de nódulos ·”satélites” en sarcoidosis




Nakatsu M et al. Large coalescent parenchymal nodules in pulmonary sarcoidosis: “sarcoid galaxy” sign. AJR 2002:

Koide T, and Tea S. Clinical significance of the “Galaxy sign” in a Japanese single-center cohort. Sarcoidosis Vasc. Diffuse Lung Dis. 2016.
Dr. César Pedrosa
“GALAXIA”. SIGNO DE LA


“Agrupación
de granulomas” en sarcoidosis





Koide T, and Tea S. Clinical significance of the “Galaxy sign” in a Japanese single-center cohort. Sarcoidosis Vasc. Diffuse Lung Dis. 2016.




Dr. César Pedrosa
GOLDEN. SIGNO DE
(Reverse S sign of Golden)
La concavidad de la cisura menor en la parte externa y la masa tumoral cercana al hilio componen la figura





Gupta P. The Golden S Sign. Radiology.2004

(Más
frecuente en LSD) (Ca. De
Golden R The effect of bronchostenosis upon the roentgen-ray shadows in carcinoma of the bronchus. AJR Am J Roentgenol 13:21-30, 1925




Dr. César Pedrosa
Dr. César Pedrosa
“HALO” Halo sign
SIGNO DEL

Hemorragia. Necrosis coagulativa rodeando necrosis central (hifas de aspergillus).

SIGNO DEL
Transitorio (primeros 10 días, luego desaparece).
Tendencia a la coalescencia. (consolidación)

Leucemia mieloide




Dr. César Pedrosa
DE Halo sign
Enf. invasiva hongos…86,9%
Aspergilosis invasiva..75,4%
Mucormicosis.............3,2%

Enf. por hongos (no moho). 1,96%
Candida.......59,3%
Inmunocompetentes
Criptococosis ….40%
Aspergilosis invasiva..20%

Opacidad en vidrio deslustrado rodeando a un nódulo/masa
Ray A et al. CT Halo sign: A systematic review. Eur J Radiol 2020/ Inmunosuprimidos.
Leucemia mieloide



Inicio. Signo presente: 90% . Después de 1semana.20%



Shroff GS et al. CT signs in the lungs. Semin Ultrasound CT MRI. 2018
Dr. César Pedrosa
“HALO”SIGNO DE
Adenocarcinoma diseminado.






Citología del esputo positiva Hanrahan L et al. It is all in the sputum: a case of non-resolving pneumonia.
BMJ Case Rep. 2014.
Ray A et al. CT Halo sign: A systematic review.Eur J Radiol 2020








HALO INVERTIDO. SIGNO DEL
Reversed halo sign” . Atoll sign.
Centro de vidrio deslustrado rodeado por un anillo o media luna de consolidación.

Neumonía organizada
Inmunosuprimidos: Mucormicosis
Aspergilosis invasiva
Periférico
Infarto
Shroff GS et al. CT signs in the lungs..
Semin Ultrasound CT MRI.2018












HAMARTOMA PULMONAR
Incidencia: 0,25%. (más frecuente).
Más en varones. 2/3:1.
Menos frecuente: Endobronquial.
Hiliar. Múltiple: 5-15%.






5-8% de los nódulos solitarios. .
Grasa generalizada o focal. (50%). Calcificaciones en “palomitas de maíz”. (5-50%) .
Umbral de detección de grasa: < 33 UH. Hochhegger B et al.
Computed Tomography Findings in Pulmonary Hamartomas: A New Fat Detection Threshold. J Thoracic Imaging 2016




Molinari F et al. Fat-containing Lesions in adult thoracic imaging. AJR.2011
Dr. César Pedrosa
”HINCHAZÓN DEL LÓBULO”
SIGNO DE LA
(Bulging fissure sign)

Consolidación lobar que debido a la cantidad y espesor de las secreciones causa desplazamiento cisural.
Descripción clásica:
Neumonía por Klebsiella del LSD




Neumonía por Klebsiella
“Bulging fissure sign” en Walker CM et al. Imaging Pulmonary infection. Classic Signs and Patterns. AJR. 2014./ Yamakawa H et al. Pulmonary Hodgkin´s Lymphoma presenting with a bulging fissure sign Intern Med 2014




Dr. César Pedrosa
”HINCHAZÓN DEL LÓBULO”
SIGNO DE LA
(Bulging fissure sign)
1. Neumonía Pneumococo (67% de los casos)
Pseudomonas

Neumonía por Klebsiella





Klebsiella (más frecuente en adquirida en la comunidad
Estafilococo
Legionella Covid-19
Tuberculosis
2. Otros. (BONO, etc.)
3. Neumonía obstructiva
4-. Hemorragia pulmonar




Dr. César Pedrosa
”HINCHAZÓN DEL LÓBULO” . SIGNO DE LA
Obstrucción bronquial con invasión tumoral del lóbulo afectado.

Yamakawa H et al. Pulmonary Hodgkin´s Lymphoma presenting with a bulging fissure sign. Intern Med 2014












HOLLEJOS DE UVA. SIGNO DE LOS
“Grape-skin” sign
Cavidad de borde fino que se forma en zona de consolidación o granulomatosa previa que ha desarrollado necrosis.



Cocidiodomicosis crónica Tuberculosis postprimaria Ca. de pulmón Hongos







Walker CM et al. Imaging Pulmonary Infection: Classic Signs and Patterns. AJR. 2014
70 años. VIH+. Baciloscopia +++

Dr. César Pedrosa
INFARTO PULMONAR EN TEP. Frecuencia de signos


Borde convexo. 46% Lóbulos inferiores. 73%


Ápex “truncado” 57%




+ de 1 infarto. 33%



Base pleural ancha. 65%

74 pacientes: Infarto presente en 32%


< realce focal parenquimatoso. 95%

Vaso grueso hacia ápex. 14%




Radiotransparencias internas. 32% Tractos densos hacia el hilio. 24%
He H et al. Pulmonary infarction: spectrum of findings on multidetector helical CT. J Thorac Imaging. 2006

Dr. César Pedrosa
INFARTO PULMONAR EN TEP. Signos locales








Espinosa LA et al. Clinical utility of multiplanar reformation in pulmonary CT angiography. AJR 2010





INTERFASE. “SIGNO DE LA
La interfase entre grasa subpleural/mediastínica, habitualmente linear y regular, se ve alterada por la presencia de fibrosis.

El signo es más frecuente en neumonía intersticial usual.
La neumonía intersticial no específica no lo presenta (además de poco panal)





Neumonía intersticial usual con severa fibrosis pulmonar y panal extenso



Chiarenza et al. Chest imaging using signs, symbols, and naturalistic images: a practical guide for radiologists and non-radiologists. Insights into Imaging. 2019./Webb WR. The idiopathic interstitial pneumonias en Webb RW and Higgins CH. Thoracic Imaging. Lippincott. 2005

JOROBA DE HAMPTON.
SIGNO DE LA Hampton,s hump





Tromboembolismo pulmonar.
Densidad homogénea

localizada en los senos diafragmáticos que termina en una cúpula que mira hacia el hilio.
Habitualmente de 3-5 cm pero puede llegar a 10 cm. Frecuente reacción pleural.






Machin
KAPOSI. SARCOMA DE
Neoplasia de bajo grado asociada al herpesvirus HHV-8 que afecta a espacios mucocutáneos.
4 variantes: Clásico, Endémico (Africa)
Yatrogénico (transplante de órganos)

Asociado a SIDA

Nódulos mal definidos bilaterales y simétricos peribroncovascular.(> 1 cm).
A veces rodeados de “vidrio deslustrado”.(signo del halo). Engrosamiento septal. Ganglios.
Afectación pleural






Afectación torácica: 45% de pacientes con lesiones dérmicas
Restrepo CS et al. Imaging Manifestations of Kaposi Sarcoma. Radiographics 2006





LACERACIÓN PULMONAR. SIGNO DE LA

Impacto fuerte. Laceración pulmonar que se rellena con aire y/o sangre.
El tejido vecino se retrae y aparecen densidades ovales o redondeadas.

Lewis BT. Imaging
Manifestations of Chest Trauma. Radiographics 2021






Precipitado.. Vagabundo. Paraplejia. Contusiones y laceraciones pulmonares rellenas de contraste. Neumotórax. Fx. costales y vertebrales. Neumotórax izdo.

Dr. César Pedrosa

Tipo 1. Rotura por compresión. Central




LACERACIÓN PULMONAR. SIGNO DE LA


Tipo 2. Rotura por desgarro. Lóbulos inferiores. Cercanas a la columna.
Tipo 3. Periféricas. Penetración por costilla rota
Tipo 4. Adherencias previas



Contusiones y laceraciones pulmonares rellenas de contraste y/o aire.
Polireddy K et al. Blunt thoracic trauma: role of chest radiography and comparison with CT-findings and literature review . Emerg Radiol 2022/ .
Lewis BT. Imaging Manifestations of Chest Trauma. Radiographics 2021

Dr. César Pedrosa
LÍNEA BLANCA PLEURAL. SIGNO DE LA


Visualización de la pleura visceral como una línea blanca cuando existe un neumotórax que separa ambas pleuras.






. Kumaresh A et al. Back to Basics – ‘Must Know’ Classical Signs in Thoracic Radiology. Thoracic Radiology. J Clin Imaging Sci 2015.


Dr. César Pedrosa
LÍNEAS DE KERLEY. SIGNO DE LAS (Kerley´s lines)
Líneas A. Líneas finas blancas radiadas desde los hilios por engrosamientos de septos.



Líneas de Kerley A.



Líneas B. Perpendiculares a la pared torácica. Más frecuentes en bases.(Septos subpleurales).

Shanks SC, Kerley P.A textbook of x-ray diagnosis.1951
Sekar T. A beeline through Sir Peter James Kerley's life
AJR 2011


Líneas de Kerley B.

Dr. César Pedrosa
LÍNEAS DE KERLEY. SIGNO DE LAS (Kerley´s
Líneas C. Líneas finas entrelazadas que dan lugar al aspecto reticular, “Reticulación”


lines)


Líneas D. Como líneas B pero en espacio retroesternal Visualización 43%. Janower 1971

Líneas de Kerley C.

Shanks SC, Kerley P.A text-book of x-ray diagnosis.1951Sekar T. A beeline through Sir Peter James Kerley's life AJR 2011 *Índice




Líneas Kerley D

Dr. César Pedrosa
LIMPIADOR DE TUBERÍAS.
SIGNO DEL (Pipe cleaner sign)




Apariencia nodular de los haces broncovasculares, en septos interlobulillares y regiones subpleurales. Recuerda los cepillos utilizados en la limpieza de tubos de humos.
Shroff GS et al . CT signs of the lungs. Semin Ultrasound CT MR. 2018.





Sarcoidosis



LIMPIADOR DE TUBERÍAS.
SIGNO DEL (Pipe cleaner sign)







Linfangitis en AdenoCa. del LM
Puede verse en linfangitis carcinomatosa,(engrosamiento liso o nodular septal interlobular)
sarcoidosis, silicosis y neumoconiosis del carbón.(Engrosamiento septal ausente)
Shroff GS et al . CT signs of the lungs. Semin Ultrasound CT MR. 2018.




LÓBULO
MEDIO SÍNDROME DEL
2 Tipos
a. No obstructivo. (bronquiectasias)

b. Obstructivo. (Tb, ganglios, Tumor)






Gudbjartsson T et al. Respiration 2012.



45 años. Hemoptisis recurrentes. Bronquiectasias del LM con colapso. Esputo Klebsiella

Dr. César Pedrosa
“LÖFGREN” SÍNDROME DE
Sarcoide alveolar “agudo”
Tobillo (más en hombres). “Eritema Nodoso” más en mujeres.
Lesiones alveolares, Eritema nodoso (EN),Uveítis. Aumento ganglionar agudo. Artritis. Curación.


Frecuente al inicio en España y países escandinavos.
Más frecuentemente encontrados en primavera.
Influencia genética
Mañá J et al. Multidisciplinary approach and long-term follow-up in a series of 640 consecutive patients with sarcoidosis. ……Spain. Medicine. 2017









Grunewald J et al. Sex-Specific Manifestations of Lofgren’s Syndrome. Am J Respir Crit Care Med.2007

Dr. César Pedrosa
LUFTSICHEL. SIGNO DEL
“Interposición del segmento ápicosuperior del lóbulo inferior entre el mediastino y el lóbulo colapsado”.

Webber. M et al. Clin Radiol. 1981.
Blakenbaker DG. Radiology 1998






Luftsichel:
Hoz o Media luna creciente






LUFTSICHEL. SIGNO DEL






La imagen es debida a la tracción que una cisura accesoria produce sobre la parte más posteroinferior del lóbulo superior izquierdo colapsado. (Dato no descrito)
Colapso de los lób. superiores o combinados con los lób. medios (67%), por rotación de una cisura accesoria inferior (64%). Davis SD. Radiology 1996/Cameron DC. Australas

Radiol 1993/Geoffrey B et al. J Thorac Imaging 2006.

Kattan KR et al.The Juxtaphrenic Peak in Upper Lobe Collapse. Radiology .1980.
Dr. César Pedrosa
LUFTSICHEL
DERECHO.
SIGNO DEL
Signo poco frecuente. Atelectasia del LSD con aire visible entre el mediastino y el pulmón colapsado. También coexiste con cisura accesoria superior derecha. (Dato no descrito)












Mazas
Dr. César Pedrosa
MASA PULMONAR
1. Definición.
Opacidad redondeada mayor de 3 cm

Carcinoma/ Linfoma
Absceso/ Neumonía redonda
Q. hidatídico
Seudotumor Metástasis/ Sarcoma Toruloma
Secuestro Hematoma
Cavidad rellena
Atelectasia redonda

Ca. NCP
2. Cavitación en masa



Carcinoma Neumonía necrotizante Tuberculosis Infarto séptico
Q. Hidatídico
Metástasis

Secuestro/Neumatocele


Carcinoma



“MENISCO”. SIGNO DEL (Air crescent sign)
Área semilunar de aire separando masa o nódulo de la pared de una cavidad

Aspergilosis invasiva Micetoma
Q. hidatídico Hematoma


Absceso Neumonía necrotizante
Bronquiectasias con moco
Papilomatosis
Walker CM et al. Imaging Pulmonary Infection: Classic Signs and Patterns. AJR. 2014
Leucemia mieloblástica con Aspergilosis aguda











MENTA POLO” SIGNO DE
LA “Polo mint” sign”

Visualización en en plano axial de un vaso con trombo en tromboembolismo pulmonar agudo.
(Recuerda a un tipo especial de polo




Wittram C, et al (. angiography of pulmonary embolism: diagnostic criteria and causes of misdiagnosis. Radiographics 2004

Chiarenza et al. Chest imaging using signs, symbols, and naturalistic images: a practical guide for radiologists and non-radiologists. Insights into Imaging. 2019.




PATRÓN MILIAR. ( Milliary pattern)
Nódulos de < 1 mm diseminados y dispuestos al azar

Tuberculosis (puede no tener fiebre)

Instilación de BCG
Micobacteria no TB





Hongos Virus.(varicella, sarampión)
Micoplasma
Criptococosis
Cocidiodomicosis
Nocardiosis/ Salmonella
Micoplasma



Dr. César Pedrosa
PATRÓN EN “MOSAICO”. (Mosaic pattern)
Hansell. DM et al. Fleischner Society: Glossary of Terms for Thoracic Imaging. Radiology 2008
Con atrapamiento aéreo

Enf. de pequeñas vías
Neumonía organizada criptogénica
Asma Bronquiolitis Constrictiva Celular


Variable: Neumonitis de hipersensibilidad “Áreas parcheadas de diferente atenuación en TC pulmonar”.



Atrapamiento aéreo infrecuente
Enf. Parenquimatosa Neumonía por Neumocistis jiroveci. Neumonía intersticial descamativa

Enf. Vascular pulmonar Hipertensión pulmonar primaria.
TEP crónico
Enf. Veno-oclusiva

Ridge CA et al. Mosaic Attenuation. AJR 2011
Dr. César Pedrosa
PATRÓN EN “MOSAICO”



VIH+. Neumonía por
pneumocistis jirovecci








Kligerman SJ et al. Mosaic Attenuation: Etiology, Methods of Differentiation, and Pitfalls. Radiographics 2015/Ridge CA et al. Mosaic Attenuation. AJR 2011
Dr. César Pedrosa
NEUMATOCELES
Neumatocele
Trauma
Infección/Hongos
Post-Tb.

Hidrocarburos
Ventilación de PP
Quiste hidatídico
Bulla
Seudoquiste (enfisema intersticial)

En niños 2-8% de casos. (85% por estafilococos)

post neumonía necrotizante Neumonía por Estreptococo viridans






Shamberger RC et al. Pneumatocele complicating hyperimmunoglobulin E syndrome (Job's Syndrome). Ann Thorac Surg. 1992.
Beigelman-Aubry C et al. Lung infections: The radiologist’s perspective. Diagnostic and Interventional Imaging. 2012.

Dr. César Pedrosa
NEUMONÍA POR COVID-19

Rx. normal..25%
Alteraciones iniciales (0-2 días). 59%
Bilaterales…………….80,6%
Vidrio deslustrado…67,7%.



Alt. reticular…………70,9%
Consolidación……..35,5%
Afectación periférica……………61,3%
Severidad máxima de hallazgos…10-12 días del inicio
Wong HYK et al. Frequency and Distribution of Chest
Radiographic Findings in Patients Positive for COVID-19.
Radiology 2020






Vancheri SG et al. Radiographic findings in 240 patients with COVID-19 pneumonia: time-dependence after the onset of symptoms. Eur Radiol 2020

Dr. César Pedrosa
NEUMONÍA LIPOIDEA
1. Exógena. (la más frecuente).
a. Aspiración /inhalación de aceite.
b. Alteraciones esofágicas. c. Alt. neuromusculares. (Parkinson, demencia, EM)
2. Endógena. (obstrucción bronquial)

Consolidación con “atenuación grasa” (áreas dependientes).






Pueden aparecer a los 30 minutos de la aspiración. Patrón de “empedrado” Bronquiectasias. Panalización



NEUMONÍA ORGANIZADA
3 tipos

a. Densidades parcheadas (más frecuente)
b Opacidad solitaria
c. Fibrosis, Nódulos múltiples, Fibrosis progresiva.
Halo invertido.

Cottin V. Cryptogenic Organizing Pneumonia
Semin Respir Crit Care Med 2012.









Dr. César Pedrosa
NEUMONITIS POR RADIACIÓN

Neumonitis evidente de 4-12 semanas después de terminar RXT. Fibrosis evidente en 3-4 meses. Estable de 912 meses.
Müller NL. 2010


Ca. de mama izquierda. 3/7/09 Radioterapia



La lesión típicamente limitada al campo de irradiación.
Müller NL. 2010






Induce neumonitis. “Tangential beam” para pared torácica.
Jung JI et al. Thoracic Manifestations of Breast Cancer and Its Therapy. Radiographics 2004

Dr. César Pedrosa
NIVEL HIDRO-AÉREO. SIGNO DEL
Indica habitualmente necrosis con líquido retenido en la cavidad



Absceso pulmonar
Aspiración Embolismo séptico. Germen habitual Anaerobios/Klebsiella. Estafilococo aureus.
Aspergilosis invasiva Mucor Walker CM et al. AJR 2014






Absceso por pseudomonas
Otros Bullas infectadas Empiema pleural Tuberculosis. Extrapulmonar Empiema

Dr. César Pedrosa




“NIVEL


HIDROAÉREO”. SIGNO DEL
La posición del nivel hidroaéreo es central en absceso pulmonar mientras está en la parte alta en empiema pleural




Absceso pulmonar por Neiseria y Est. Viridans.
“Borde mal definido” Empiema pleural en adicto. “Borde bien definido”




Dr. C Pedrosa
NÓDULOS MÚLTIPLES CON CALCIO/HUESO
METÁSTASIS
METÁSTASIS
Sarcomas esp. Condrosarcoma, Osteosarcoma
Sarcoma sinovial





CARCINOMAS MUCINOSOS
GI, Ovario. Mama
Ca medular tiroides (raro)








Metástasis de condrosarcoma de pierna derecha
Wale DJ et al. Extraosseous Findings on Bone Scintigraphy Using Fusion SPECT/CT and Correlative Imaging. AJR 2015/ Kanne JP. Pulmonary calcification. en EXPERT ddx. Chest. Amirsys. 2011.

Dr. César Pedrosa
NÓDULOS MÚLTIPLES CON CALCIO/HUESO
Tuberculomas que crecen TUBERCULOMAS


Metástasis
Infección granulomatosa

Embolismo séptico
Enf. de Wegener
Sarcoidosis
Linfoma
Nódulos reumatoideos
Neumonía por varicella









Goo JM, et al. Pulmonary tuberculoma evaluated by means of FDG PET: findings in 10 cases. Radiology. 2000./Chang JM et al.
False Positive and False NegativecFDG-PET Scans in Various Thoracic Disease Korean J Radiol 2006./ Pipavath S. Multiple welldefined nódulos en Stern-Gurney. EXPERTddx. Chest. Amirsys.2011

Dr. César Pedrosa
NÓDULOS REUMATOIDEOS




+/- 32% de pacientes con AR.
Subpleurales y cisurales







Exposito AJ et al. Thoracic Manifestations of Rheumatoid Arthritis. Clin Chest Med. 2019.
Dr. César Pedrosa
“NUDILLO” Knuckle sign
SIGNO DEL


Stop abrupto de una arteria pulmonar secundaria a un tromboembolismo pulmonar







Tromboembolismo pulmonar. Densidad anormal en pulmón izquierdo debida a adenocarcinoma.

Dr. César Pedrosa
a. Inflamatorias
1.Bronconeumonía

Estafilococos
Legionella Gram negativos
Estreptococos
Klebsiella
Seudomonas
Anaerobios
Neumocistis 2. Tuberculosis










Dr. César Pedrosa
OPACIDADES MULTIFOCALES
c. Neoplasia
AdenoCarcinoma
Metástasis




1.Consolidación múltiple d. Otros Neumonía organizada Neumonía eosinófila
Neumonía organizada

Ca. Cola páncreas


Neumonía lipoidea




Dr. César Pedrosa
“PALOMITAS DE MAÍZ” . SIGNO DE LAS
“Pop corn sign”
Calcificaciones “grumosas” en un hamartoma. +/_ 10%



Tumor benigno más frecuente “Mezcla desorganizada” de tejido adiposo, epitelial y cartilaginoso T. Solitario. Nódulos bien definidos < de 4 cm de diámetro
Periferia pulmonar
Pueden crecer lentamente TC: Grasa en 50-60%






Chiarenza et al. Chest imaging using signs, symbols, and naturalistic images: a practical guide for radiologists and non-radiologists. Insights into Imaging. 2019.


Dr. César Pedrosa
PATRÓN DE PANALIZACIÓN.
Múltiples espacios “quístico”
Habitualmente en bases y Áreas laterales
Neumonía Interst. Usual
(Fibrosis idiopática)

Enf. colágeno (AR, etc.)
Fibrosis por drogas
Asbestosis

Honey comb pattern

Estadio final de Neumonitis de hipersensibilidad
Sarcoidosis
Distrés Resp. Agudo
Radiación
Neumonía interst. no específica (NINE)

Neumonía intersticial usual Webb. 2005/ Hansell DM. Radiology







PANCOAST. SÍNDROME
DE

Masa apical acompañada de dolor del hombro, síndrome de Horner y atrofiade los músculos de la mano. 5% de los Ca. de pulmón. 95% de los casos debido a a Ca. de pulmón no microcítico.



Adenocarcinoma con destrucción de 1ª costilla y linfangitis peritumoral.


Puede deberse también a linfoma, neoplasias pleurales, ca de tiroides, infecciones, hongos, etc.





Hutchings HE et al. Treatment patterns and outcomes in patients with Pancoast tumors: a national cancer database analysis . J Thorac Dis . 2023 / Bruzzi JF, et al.. Imaging of non–small cell lung cancer of the superior sulcus. Radiographics 2008.
Dr. César Pedrosa
“PERLAS NEGRAS” AGRUPACIÓN. SIGNO DE LAS



“Cluster of black pearls”






Ganglios en sarcoidosis con puntos negros visibles. Ramana. RV et al. The “Cluster of black pearls” sign of sarcoid lymphadenopathy: a new sign on thin-section contrast-enhanced multidetector CT. Clinical Radiology 2017

Dr. César Pedrosa
“PICO YUXTAFRÉNICO”. SIGNO DEL (Yuxtaphrenic peak sign)

Formación de un pico en la superficie diafragmática en los casos de colapso de los lóbulos superiores, debido a la tracción que produce una cisura accesoria .










Kattan KR et al.The Juxtaphrenic Peak in Upper Lobe Collapse. Radiology .1980. Colapso de los lób. superiores o combinados con los lób. medios (67%), por rotación de una cisura accesoria inferior (64%). Davis SD. Radiology 1996/Cameron DC. Australas Radiol 1993/Geoffrey B et al. J Thorac Imaging 2006.

Dr. César Pedrosa
PULMÓN “BLANCO” UNILATERAL


Ca de pulmón
Ca de pulmón


CON PÉRDIDA DE VOLUMEN
1. Atelectasia masiva
2.Postneumectomía
3. Pulmón destruido (destruens).
4. Agenesia pulmonar
5. Fibrotórax.



Modificado de Lillington y Dáhnert


CON AUMENTO DE VOLUMEN
1. Hernia diafragmática.
2. Derrame pleural masivo.
3. Tumor mediastínico

4. Malformación adenomatoidea.
5.. Mesotelioma pleural.
6. Aneurisma
7. Masa de pared torácica
VummidI D, Kanne JP. Unilateral opaque hemithorax en Expert ddx. Chest. Amirsys. 2011

Dr. César Pedrosa
PULMÓN “BLANCO” UNILATERAL
b. No desviación mediastínica ni traqueal

c. Desviación ipsilateral traqueal + mediastínica a. Desviación contralateral mediastínica + traqueal



Derrame pleural masivo en neumonía



Derrame pleural + Atelectasia = Ca. de pulmón


2. Variantes Neumonía en paciente con Neumectomía izda.
VummidI D, Kanne JP. Unilateral opaque hemithorax en Expert ddx. Chest. Amirsys. 2011




Dr. César Pedrosa
QUISTE HIDATÍDICO PULMONAR



SIGNOS DEL


A. Membranas colapsadas (signo de la serpiente) B A C
B. Membranas sueltas.
Dec. Lat. (signo del menisco)


C. Nivel H-A. Aire entre periquística y membrana laminada del quiste Signo de Cumbo
Pedrosa I et al. Hydatid disease: radiologic and pathologic features and complications. Radiographics 2000

Dr. César Pedrosa
LESIÓN “QUÍSTICA MÚLTIPLE.
Linfangioleiomiomatosis





Mujeres en edad gestante
Quistes de pared fina No distribución zonal Bilaterales
Patrón reticular (si muchos)
Neumotórax frecuente Hallazgos similares a la Esclerosis tuberosa.







LESIÓN “QUÍSTICA MÚLTIPLE.
Histiocitosis de Langerhans
Jóvenes fumadores.
(entre 20-40 años)
La mayoría sin síntomas.

Neumotórax: 5%.
Complicación: Diabetes insípida.
1º Nódulos
2º. Quistes. Progresan a formas extrañas.
Suelen dejar libres las bases pulmonares









Raoof L et al. Cystic Lung Diseases, Chest 2016
Dr. César Pedrosa
LESIÓN “QUÍSTICA”
UNICA
c. Origen congénito
Masa congénita de proliferación adenomatoidea. La mayoría confinadas a 1 lóbulo. Irrigación PA En comunicación con árbol bronquial



Malformación quística adenomatoidea
Enfisema lobar congénito

Atresia bronquial
Quiste broncogénico

Intrapulmonar/Pleural (Nakagawa. J. Thorac. Imaging.2008)
Secuestro Hamartoma quístico mesenquimal
Souza. J. Thorac. Imaging.2009



Rosado-de-Christenson ML et al.. Congenital cystic adenomatoid malformation of the lung. Radiographics. 1991;
Malformación quística adenomatoidea


Dr. César Pedrosa
RAÍLES DEL TREN. SIGNO DE LOS
Railroad track sign
Un émbolo dentro de una arteria pulmonar vista en sentido longitudinal







Chiarenza et al. Chest imaging using signs, symbols, and naturalistic images: a practical guide for radiologists and non-radiologists. Insights into Imaging. 2019.




Dr.César
RAYOS DEL SOL. SIGNO DE LOS
(Sunburst sign)






Una masa o nódulo pulmonar con bordes espiculados e irregulares que corresponden a vasos distorsionados y septos engrosados. Muy sugerente de lesión maligna.


VIH+. Fumador Adenocarcinoma

O’Donovan PB (1997) citado por:
Chiarenza et al. Chest imaging using signs, symbols, and naturalistic images: a practical guide for radiologists and non-radiologists. Insights into Imaging. 2019.

*Índice
Dr. César Pedrosa
RENDU-OSLER. SÍNDROME DE
Criterios de Curaçao
1. Epistaxis recurrentes espontáneas
2. Telangiectasias mucocutáneas
3. MAV de órganos viscerales
4. Parientes en primer grado con similar entidad.


(3 de los 4 criterios necesarios)
1er órgano afectado por MAV: pulmón. (45%). Hemoptisis frecuente Sangrado GI
Síndrome hipercinético








Llantz KE et al. Arteriovenous Malformations in the Setting of Osler-Weber-Rendu:What the Radiologist Needs to Know. Current Problems in Diagnostic Radiology 2022).

Dr. César Pedrosa



FRECUENTES
PATRÓN LINEAR O “SEPTAL”

Engrosamiento de septos interlobulillares (líneas de Kerley) y del intersticio broncovascular

Edema cardiogénico
Linfangitis carcinomatosa
Sarcoidosis
Neumonía intersticial
usual
MENOS FRECUENTES O RARAS
Proteinosis alveolar
Enfermedad veno-oclusiva
Infiltración leucémica
Amiloidosis

Linfangioleiomiomatosis
Neumonía eosinófila aguda
Estenosis vena pulmonar

Chung JH. Interlobular septal thickening. en Stern-Gurney. Expertddx. Chest. 2011. Dahnert. 2011
Dr. César Pedrosa
PATRÓN SEPTAL BILATERAL



Linfangitis carcinomatosa

Mama, Estómago, Páncreas, Pulmón, Próstata
Linfoma maligno Sarcoidosis
Silicosis

Edema intersticial crónico
Mod. de Murata K et al . AJR 1996


Moubax K et al. Pulmonary lymphangitic carcinomatosis as a primary manifestation of gastric carcinoma in a young adult: a case report and review of the literature. BMC Research Notes 2012
Linfangitis carcinomatosa




PATRÓN SEPTAL UNILATERAL


Linfangitis carcinomatosa broncogénico Ca. de mama









Linfangitis carcinomatosa de Ca. broncogénico
Moubax K et al. Pulmonary lymphangitic carcinomatosis asa primary manifestation of gastric carcinoma in a young adult: a case report and review of the literature. BMC Research Notes 2012.

Dr. César Pedrosa
SEPTO ARROSARIADO. SIGNO
DEL
“Beaded septum” sign

Engrosamiento irregular y nodular de septos interlobulares. Crecimiento tumoral en septos. Linfangitis carcinomatosa
Sarcoidosis (raro)


Ren H et al. Computed








Dr. César Pedrosa
SILUETA. SIGNO DE LA
“Silhouette sign “







Atelectasia del LM que borra el borde cardiaco.
Desaparición de la interfase“normal” entre el aire pulmonar y las estructuras de densidad“ agua ” del tórax, (diafragma, aorta y borde cardiaco) por densidad pulmonar anormal añadida




(Alteración de las interfases normales).



Empiema pleural posterior que no borra el borde cardiaco

Felson B. Localization of intrathoracic lesions by means of the posteroanterior roentgenogram. Radiology 1950.
Dr. César Pedrosa


Borde derecho alto borrado por consolidación anterior

Borde derecho medio. Borrado por masa anterior.

Masa posterior que no borra el borde mediastínico
SILUETA. SIGNO DE LA “Silhouette sign “









2a Borde derecho bajo. Consolidación anterior que borra el borde mediastínico



Borde derecho bajo. No borrado por consolidación posterior (atelectasia del LID)
Felson B. Localization of intrathoracic lesions by means of the posteroanterior roentgenogram. Radiology 1950

Dr. César Pedrosa


SILUETA. SIGNO DE LA “Silhouette sign “


Borde izquierdo alto Arco aórtico no borrado por masa anterior




5b. Ganglios de la VAP que borra el arco aórtico



Borde izquierdo bajo
1a. Borde cardiaco borrado por consolidación de la língula



1b. Atelectasia del LII que no borra el borde cardiaco

Felson B. Localization of intrathoracic lesions by means of the posteroanterior roentgenogram. Radiology 1950
Dr. César Pedrosa
SUELTA DE GLOBOS. SIGNO DE LA (Cannon
ball sign)
Múltiples formaciones redondeadas en pulmón

Metástasis de:
Ca. Renal






Coriocarcinoma gestacional y no gestacional
Ca. Testicular/Ca. Colónico
Sarcomas/Tiroides
T. gastrointestinales
Lakshman A et al. Cannon Ball Lung Metastases
froma Previously Unreported Primary. Journal of Clinical and Diagnostic Research. 2017

Sarcoma sinovial



Dr. César Pedrosa
SWYER- JAMES-MCLEOD SÍNDROME
DE
Lesión rara con reducción de la vasculatura de un pulmón, distensión alveolar con o sin bronquiectasias debido a Bronquiolitis obliterante en la infancia

Criterios diagnósticos:


1. Pérdida unilateral de volumen pulmonar con Hiperclaridad en la Rx. de tórax.
2. Reducción en vascularidad en TC.
3. Pérdida de perfusión (Tc-99)





Dirweesh A, Alvarez C, Khan M, Shah N. A unilateral hyperlucent lung - Swyer-James syndrome: .A case report and literature review. Respir Med Case Rep. 2017;20:104-106. / Chlapoutakis S et al SRecurrent Exacerbations of C.nic Obstructive Pulmonary Disease
Reveal Swyer-James-MacLeod Syndrome in a 63-year-old Patient. Cureus 2021

Dr. César Pedrosa
TORMENTA DE NIEVE SIGNO DE LA (Snow storm sign)



Múltiples nódulos de pequeño tamaño en relación con tumores “vasculares.
DD: Tb miliar, Hongos
Umeki S. Association of miliary lung metastases and bone metastases in bronchogenic carcinoma. Chest. 1993/Chiarenza et al. Chest imaging using signs, symbols, and naturalistic images: a practical guide for radiologists and non-radiologists Insights into Imaging. 2019.
Adenoca. de LSI


Tumores:
Tiroides
Células renales
Mama
Melanoma
Páncreas
Osteosarcoma
Enfermedad trofoblástica AdenoCa. de pulmón.



Sarcoidosis, Varicela Cortesía Dra. P Fraga



TRAUMA TORÁCICO
Contusión pulmonar
Áreas de hemorragia pulmonar.
Pueden no verse en la Rx. inicial hasta en 33% de los casos.

(Tiempo medio de visualización: 6 horas).
Puede llegar a 48 horas.






Dato clave: Coincidencia de las lesiones en áreas en contacto con costillas
TC: áreas adicionales no visibles en Rx. convencional.




Polireddy K et al. Blunt thoracic trauma: role of chest radiography and comparison with CT—findings and literature review . Emerg Radiol 2022.


Dr. César Pedrosa



3 DENSIDADES. SIGNO DE LAS
“Headcheese”
sign

Coexistencia de tejido normal, densidad aumentada y atrapamiento aéreo.
Neumonitis de Hipersensibilidad
Sarcoidosis
Neumonía intersticial descamativa
Infección pulmonar con bronquiolitis




Neumonitis de Hipersensibilidad. (palmas)

Chiarenza et al. Chest imaging using signs, symbols, and naturalistic images: a practical guide for radiologists and non-radiologists. Insights into Imaging. 2019.
Dr. César Pedrosa
TRIANGULO SUPERIOR. SIGNO DEL “Upper
triangle sign”


Normal
Desviación de la Línea de unión anterior en colapso del LID.













Kattan KR et al. Superior mediastinal shift in right lower lobe collapse. “The upper triangle sign”. Radiology. 1975.
Dr. César Pedrosa
“VASO PROMINENTE”. SIGNO DEL
Engrosamiento de vasos hacia el ápex de un infarto en TEP (32%)











Revel M-P et al. Is it possible to recognize pulmonary infarction o multisection CT images?. Radiology 2007
Bray TJP et al. Multimodality imaging of pulmonary infaction. Eur J Radiol 2014

Dr. César Pedrosa
“VASO IRRIGANTE” . SIGNO DEL
Feeding vessels sign”.
Un vaso bien definido que va directamente a un nódulo o masa.

Embolismo séptico
Infarto pulmonar
Metástasis
hematógena
Fístula AV
Tumor. 18% de los casos





Chiarenza et al. Chest imaging using signs, symbols, and naturalistic images: a practical guide for radiologists and non-radiologists. Insights into Imaging. 2019.

Shroff GS et al . CT signs of the lungs. Semin Ultrasound CT MR. 2018.


Diabetes. Ca. de próstata. Émbolos sépticos. Estafilococo

Dr. César Pedrosa
“VASO
IRRIGANTE”
. SIGNO DEL Feeding vessels sign”.

Un vaso bien definido que va directamente a un nódulo o masa.


En 58% de los tumores el vaso es “dislocado” por el tumor y se visualiza en TC entrando periféricamente al nódulo.





Adenocarcinoma
Chiarenza et al. Chest imaging using signs, symbols, and naturalistic images: a practical guide for radiologists and non-radiologists. Insights into Imaging. 2019.
Murata K et al. Pulmonary metastatic nodules: CT-pathologic correlation. Radiology 1992

Dr. César Pedrosa
VÍAS DEL TRANVÍA. SIGNO DE LAS
(“Tram lines” )
Visualización de las paredes de los bronquios dilatados en bronquiectasias











PATRÓN EN VIDRIO DESLUSTRADO
“ground-glass pattern” b. Hallazgos en TC



Alvéolos parcialmente rellenos: Inflamación aguda
Fibrosis inicial

1. Áreas de alta atenuación
2. Distribución: Márgenes mal definidos, no anatómicos
3. Vasos normales no obliterados por la densidad
Hemoptisis en Wegener






PATRÓN EN VIDRIO DESLUSTRADO

1. Neumonía atípica (pneumocistis, herpes, CMV, coronavirus)



Granulomatosis con poliangitis. (WEGENER). Hemorragia pulmonar

2.Relleno alveolar agudo (sangre, edema, etc.)
3. Toxicidad por drogas
4. Enf. Infiltrativa difusa Neumonitis intersticial, Proteinosis alveolar, BONO, etc.)



Triada clásica: Pulmón (95%).Senos y tracto respiratorio superior (75-90%). Riñones (80%).
Ananthakrishnan L et al. Wegener's granulomatosis in the chest: high-resolution CT findings. AJR 2009 Yamasaki M et al. Multiple patchy pulmonary consolidation in granulomatosis with polyangiitis. Respirology Case Reports, 2020


Dr. César Pedrosa
PATRÓN EN VIDRIO DESLUSTRADO


Covid-19. (>85%)
Vidrio deslustrado
Bilateral Periférico
Basal

Neumonía bacteriana
Neumonía viral
Citomegalovirus. > 75%

Adenovirus. 50-75%
Herpex simplex. > 75%
Varicella zoster
Meta- neumovirus. 10-25%
Influenza Sarampión. 10-25%
Neumonía Pneumocistis

Neumonía intersticial inespecífica Descamativa
Neumonía organizada

Neumonía de hipersensibilidad “Vaping”. (cigarrillo electrónico)
Toxicidad por drogas
Edema pulmonar

Aspiración
Hemorragia alveolar difusa
Proteinosis alveolar
Neumonía eosinófila

Parekh M et al. Review of the Chest CT Differential Diagnosis of Ground-Glass Opacities in the COVID Era. Radiology 2020
Dr. César Pedrosa
WESTERMARK” . SIGNO DE
Signo de la hiperclaridad local
Oligohemia local distal a una arteria pulmonar ocluida por TEP

Poco frecuente.(8%)
Worsley DF et al. Chest Radiographic Findings in Patients with Acute Pulmonary Embolism: Observations from the PIOPED Study. Radiology 1997/Moore AJE et al. Imaging of pulmonary embolism: an update. Cardiovasc Diagn Ther 2018










WINDEMERE” . SÍNDROME DE LADY
Forma indolente. Supresión de la tos. Língula y LM los más frecuentemente afectados. Bronquiectasias.
Coexistencia con nódulos centrilobulillares y patrón en mosaico muy sugerente.


Micobacteria atípica
Frecuencia en “clusters” familiares. Factores genéticos de sensibilidad del huésped a la infección pulmonar.








Colombo RE et al. Familial Clustering of Pulmonary Nontuberculous Mycobacterial Disease. Chest 2010./ Olivier KN. Lady Windermere Dissected: More Form Than Fastidious. Ann Am Thorac Soc. 2016/Martínez S et al. The many faces of pulmonary Nontuberculous Mycobacterial infection. AJR. 2007
Dr. César Pedrosa
Dr. César Pedrosa